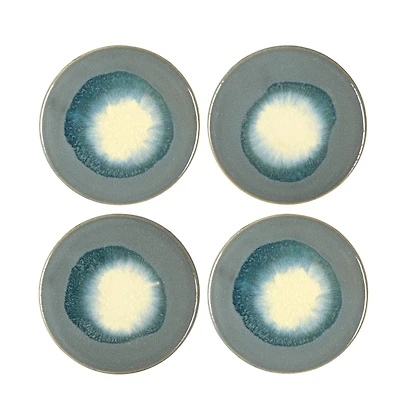
Hello Honey® Reactive Glaze Stoneware Coasters Set

Home
Hello Honey® 21" Reactive Glaze Stoneware Table Lamp with Cockatoo Print Velvet Shade and Inline Switch
Michaels
Loading Inventory...
Hello Honey® 21" Reactive Glaze Stoneware Table Lamp with Cockatoo Print Velvet Shade and Inline Switch in Chattanooga, TN
From Hello Honey
Current price: $171.99

Michaels
Hello Honey® 21" Reactive Glaze Stoneware Table Lamp with Cockatoo Print Velvet Shade and Inline Switch in Chattanooga, TN
From Hello Honey
Current price: $171.99
Loading Inventory...
Size: ONE SIZE
This stunning, tropical table lamp showcases a stoneware base in a naturally variating reactive gaze topped with a bold cockatoo print velvet drum shade. Display it in a foyer, dining room, or living area to instantly create the perfect atmosphere for entertaining guests.Details: Multicolored 11.8" x 11.8" x 21" Bold cockatoo print shade Reactive glaze base Inline switch Maximum 40 watt bulb required, not included 100% stoneware and velvet materials For indoor use
This stunning, tropical table lamp showcases a stoneware base in a naturally variating reactive gaze topped with a bold cockatoo print velvet drum shade. Display it in a foyer, dining room, or living area to instantly create the perfect atmosphere for entertaining guests.Details: Multicolored 11.8" x 11.8" x 21" Bold cockatoo print shade Reactive glaze base Inline switch Maximum 40 watt bulb required, not included 100% stoneware and velvet materials For indoor use